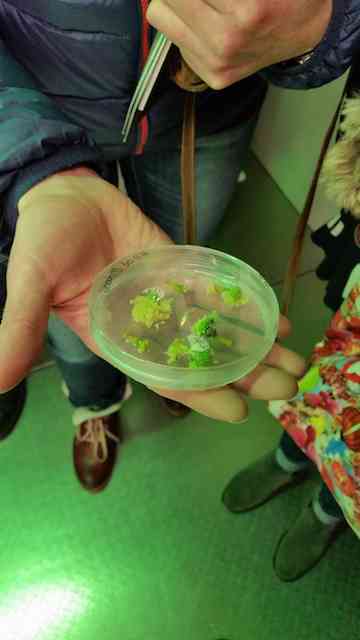

- Home
- Aktuelles
- Ansprechpartner
- Ganztag
- Schulprofil
- Schulleben
- IServ
Exkursion der MINT-Lehrerinnen und -Lehrer zum Lehrstuhl für Bio-Ingenieurwesen der TU Dortmund
Auf Einladung des VDE (Verband der Elektrotechnik Elektronik Informationstechnik e.V.) haben MINT-Lehrerinnen und -Lehrer unserer Schule den Lehrstuhl für Bio-Ingenieurwesen der TU Dortmund besucht.
Gemeinsam mit MINT-Kolleginnen und -Kollegen des Gymnasiums Petrinum konnten sich unsere Lehrkräfte einen Überblick über den Lehrstuhl Bio-Ingenieurwesen verschaffen, der von Ex-Hittorf-Schüler Prof. Dr. Oliver Kayser geleitet wird. Nach einem kurzen Vortrag über die Inhalte der verschiedenen Studiengänge und der aktuellen Forschungsprojekte, erfolgte eine Besichtigung der Labore.
Anschließend besuchten die Kolleginnen und Kollegen den Vortrag von Dr.-Ing. Andre Braunmandl vom BSI (Bundesamt für Sicherheit in der Informationstechnik) zum Thema „IT-Sicherheitskonzepte für Industrie 4.0“ der durch den VDE an der TU Dortmund ausgerichtet wurde.
Zwischen den Veranstaltungen blieb ausreichend Zeit zum kollegialen Austausch der Lehrkräfte beider Schulen, um die Zusammenarbeit auf der MINT-Ebene zu intensivieren.
Zusammen mit Dipl.-Ing. Martin Hölscher vom VDE strebt das Hittorf-Gymnasium eine intensivere Vernetzung mit Industriebetrieben aus der Region an. Schülerinnen und Schülern soll so erleichtert werden, ihren Interessen im Bereich MINT während des Praktikums in der Sekundarstufe I nachzugehen. Schülerinnen und Schüler der Q1 sollen ebenfalls die Möglichkeit erhalten, im Rahmen der Facharbeit ein praxisnahes Thema mit Unterstützung der Betriebe zu untersuchen.